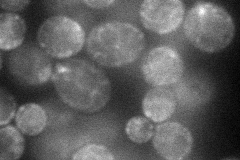
YLR084C
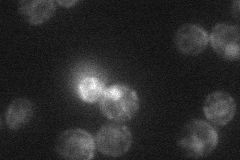
YLR084C
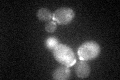
YLR084C
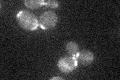
YLR084C

View description
N-glycosylated protein involved in the maintenance of bud site selection during bipolar budding; localization requires Rax1p; RAX2 mRNA stability is regulated by Mpt5p
Localization:
Intensity:
Fold change:
Significance:
-
C’ GFP library in SD

cell periphery:bud neckN/A -
N' NOP1pr-GFP in SD
ER,bud neck49.195 -
N' TEF2pr-mCherry in SD
ER,bud neck17.6035 -
N' NATIVEpr-GFP in SD

ambiguous21.9762 -
N' TEF2pr-VC and Cyto-VN in SD

#N/A0 -
C’ GFP library in SD+DTT
cell periphery.bud neck34.930.94No -
C’ GFP library in SD+H2O2

cell periphery.bud neck37.851.02No -
C’ GFP library in Starvation Media
cell periphery,bud neck27.180.73No -
C’ GFP library on the background of Pup2-DaMP

cell periphery:bud neck -
C’ GFP library on the background of CCT mutant

cell periphery:bud neck44.82721.2114No
